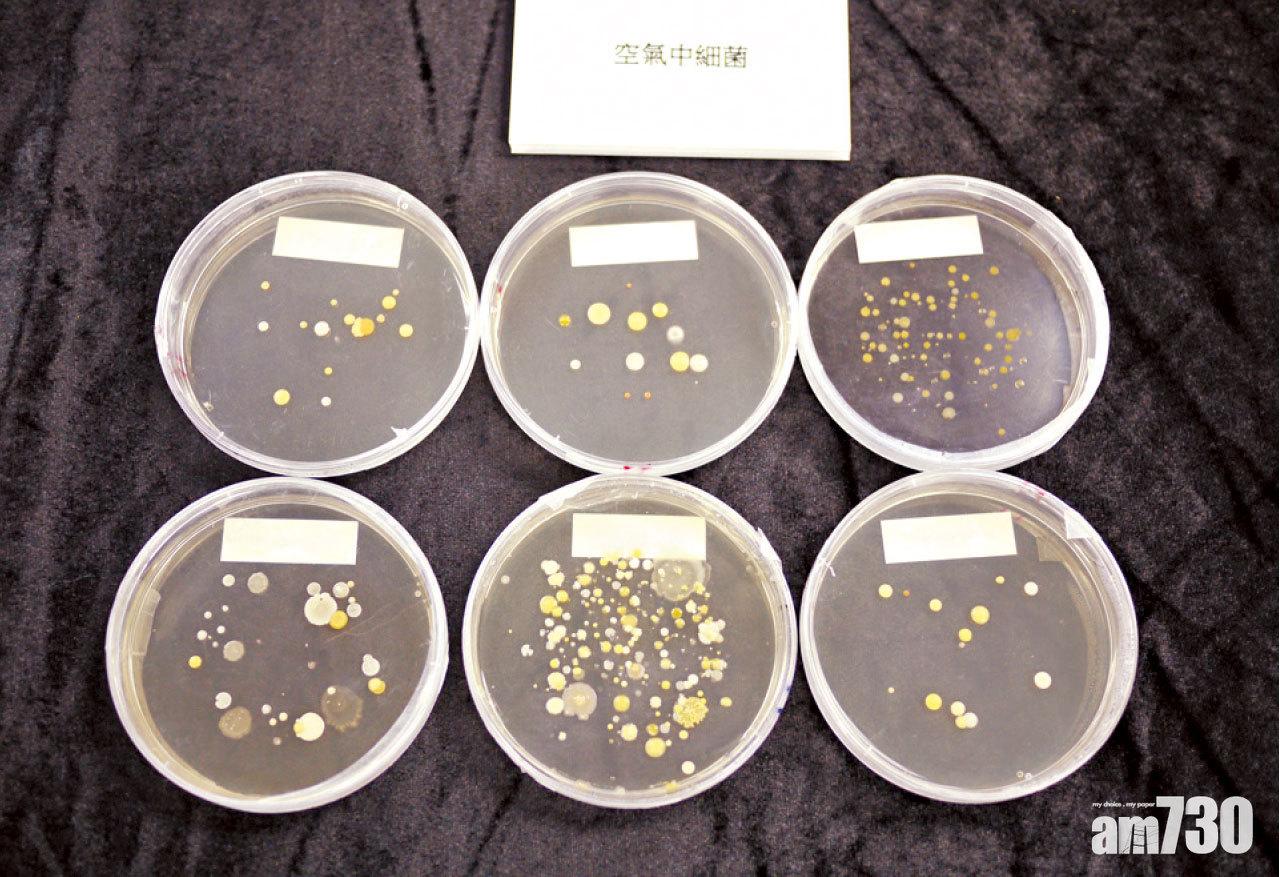

根據世衞空氣質素指引,最理想是PM10懸浮粒子少於20µg/m3、PM2.5懸浮粒子少於10µg/m3,但香港浸會大學生物系早前的一項實驗顯示,香港50個室內測試點中,大部分地區均未達標,即使在家中也避不開懸浮粒子、總發揮性化合物(TVOCs)、細菌、霉菌等,容易引致鼻敏感,或使傷風感冒演變成鼻竇炎。
耳鼻喉科專科醫生何志謙表示,如果室內空氣污染物多,身體會出現一些過敏反應,如咳嗽、打噴嚏、流鼻水、流眼水、鼻及眼睛痕癢等,如果長期吸入甲醛等有毒物質,甚至增加患癌風險。兒童、長者、孕婦、長期病患者如糖尿病人、哮喘及鼻敏感患者,更特別容易受到影響。


(左起)浸大生物系高級研究員黃兆華博士、賴嘉雯、何志謙認為提升室內空氣質素,可減低誘發鼻敏感、哮喘等風險。
有效清除污染物
香港浸會大學生物系副教授賴嘉雯博士在2018年12月至今年3月進行的一項調查中,發現78%受訪者認為香港的室內空氣質素有問題,主要是多塵、有異味及霉菌。受訪者亦嘗試過用空氣清新機、打掃及增加通風來解決問題,但效果未必令人滿意。賴嘉雯及研究團隊針對空氣清新機的效用,在香港50個地點作實地測試,「以一款潔淨空氣量達300CFM的空氣清新機,用超高速模式運行10分鐘,污染物的清除率中位數可達PM2.5懸粒子65%、TVOCs 59%、霉菌>83%、細菌>87%。」即使在一些特別的環境,例如遇上霧霾的日子、有吸煙的殘留物質、多塵及煮食環境、有寵物異味等,空氣清新機亦有相若效能。

避免接觸致敏原
何志謙亦分享了一些個案,一名45歲的女士,在2月中旬患上感冒,到3月初仍未斷尾,有咳嗽及喉嚨痕的症狀,用內窺鏡檢查發現鼻黏膜腫脹,鼻腔很亦有很多鼻黏液,確診患上鼻敏感,並且對塵蟎及狗的皮屑有輕度過敏。醫生處方噴鼻藥及抗組織胺藥物之外,亦著她每天以生理鹽水洗鼻,以及使用阻隔塵蟎的床套。何志謙亦提醒,「若有敏感症狀,最好避免接觸致敏原,所有有效清潔的方法如勤打掃、淨化空氣等都會對控制病情有幫助。」

空氣中亦含有細菌和霉菌或其孢子,長期吸入會影響健康。
空氣清新機使用建議
在空氣清新機的使用方面,賴嘉雯亦有些建議,「一般空氣清機會於機身前方及兩邊抽風,然後於機頂吹出潔淨空氣,故擺放宜置於牆邊,讓潔淨空氣可於室內對流,傳遍整個空間。另要留意出入風位不宜有阻礙,或者讓潔淨空氣經窗戶或抽氣扇流失,令淨化效能下降。」

















